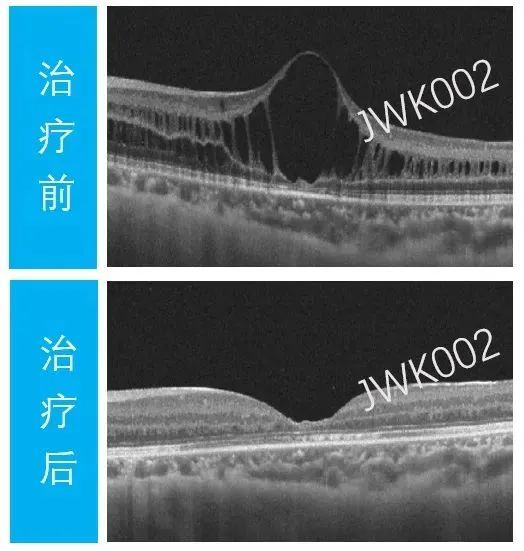
02.jpg

2025-03-18 00:00:00來源:微譜生物科技瀏覽量:505
2025年3月15日,微譜生物科技合作伙伴成都金唯科生物科技有限公司(以下簡稱“金唯科”)宣布,其自主研發(fā)的針對X連鎖視網(wǎng)膜劈裂癥的基因治療I類創(chuàng)新藥“JWK002注射液”臨床試驗(IND)申請獲得國家藥品監(jiān)督管理局藥品審評中心(CDE)受理,有望成為國內(nèi)首個針對X連鎖視網(wǎng)膜劈裂癥的基因治療藥物注冊臨床試驗。此前,JWK002注射液已獲美國FDA孤兒藥資格認(rèn)定(ODD)和兒科罕見病資格認(rèn)定(RPDD)。
微譜生物科技作為生物藥質(zhì)量與安全研究領(lǐng)域的專家,憑借過硬的技術(shù)實力與豐富的項目經(jīng)驗為該項目IND申報提供了專業(yè)的細(xì)胞庫檢定服務(wù)!
—— 金唯科AAV基因治療FDA孤兒藥IND申請獲CDE受理

▲?圖源?| CDE官網(wǎng)
X連鎖視網(wǎng)膜劈裂癥(X-linked retinoschisis,XLRS)是一種X連鎖的隱性遺傳疾病,由視網(wǎng)膜劈裂蛋白1(RS1)基因突變引起,其以不同程度的視力下降、視野缺損、黃斑中心凹劈裂以及視網(wǎng)膜電圖b波下降為主要特征。XLRS主要影響男性,通常在兒童早期被診斷,患者視力障礙程度各不相同,嚴(yán)重時可出現(xiàn)視網(wǎng)膜脫離、玻璃體積血等并發(fā)癥,臨床治療以隨訪觀察、碳酸酐抑制劑等藥物及針對其并發(fā)癥治療為主,尚無有效的臨床治療方法。
JWK002注射液是由金唯科自主研發(fā)的腺相關(guān)病毒(AAV)基因治療產(chǎn)品,JWK002通過對靶向血清型篩選和基因表達(dá)元件等進行系統(tǒng)設(shè)計,可迅速在視網(wǎng)膜細(xì)胞中恢復(fù)RS1蛋白的表達(dá),從而改善患者的視網(wǎng)膜結(jié)構(gòu)及功能。
此前在四川大學(xué)華西醫(yī)院開展的IIT臨床研究中,已經(jīng)完成多例受試者的給藥和超過1年的隨訪。結(jié)果顯示,所有治療眼均觀察到最佳矯正視力(BCVA)的顯著改善、中央視網(wǎng)膜厚度(CRT)的顯著下降、視網(wǎng)膜劈裂腔的完全閉合,且還觀察到大多數(shù)治療眼視網(wǎng)膜光敏度的改善。 ▲?治療后,患者視網(wǎng)膜劈裂腔恢復(fù)正常 圖源:金唯科生物官微
金唯科生物聯(lián)合創(chuàng)始人、CEO
楊陽研究員 表示:
“從JWK002注射液的IIT臨床研究的持續(xù)跟蹤結(jié)果來看,藥物的安全性和耐受性良好,起效劑量低,患者只需要一次給藥,無需輔助治療,給患者帶來了極大的便利性。IIT臨床結(jié)果將為我們推進臨床一期奠定堅實基礎(chǔ),我們將在IND獲批后,加速推進臨床進度,以使更多患者受益?!?/p>